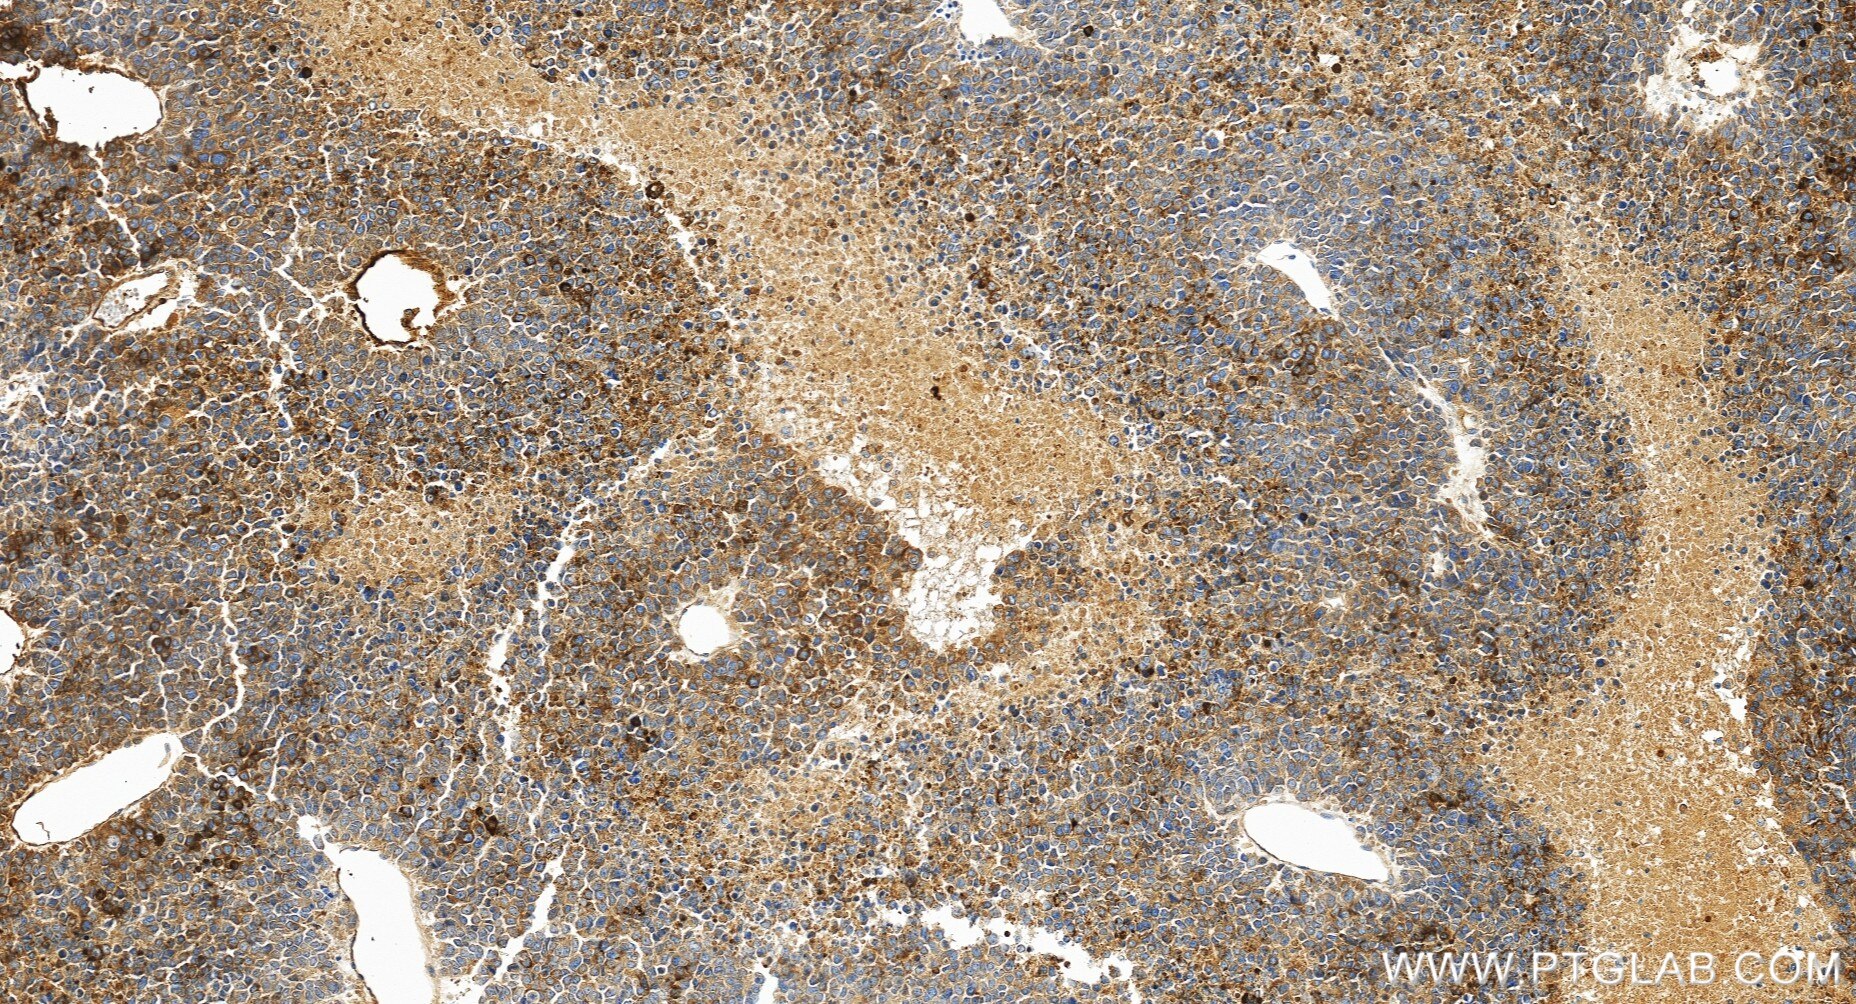
Immunohistochemistry (IHC) staining of human liver cancer tissue using AFP Recombinant monoclonal antibody (82982-6-RR)

Tested Applications
| Positive WB detected in | human placenta tissue |
| Positive IHC detected in | human liver cancer tissue, human liver tissue Note: suggested antigen retrieval with TE buffer pH 9.0; (*) Alternatively, antigen retrieval may be performed with citrate buffer pH 6.0 |
Recommended dilution
| Application | Dilution |
|---|---|
| Western Blot (WB) | WB : 1:5000-1:50000 |
| Immunohistochemistry (IHC) | IHC : 1:500-1:2000 |
| It is recommended that this reagent should be titrated in each testing system to obtain optimal results. | |
| Sample-dependent, Check data in validation data gallery. | |
Product Information
82982-6-RR targets AFP in WB, IHC, ELISA applications and shows reactivity with human samples.
| Tested Reactivity | human |
| Host / Isotype | Rabbit / IgG |
| Class | Recombinant |
| Type | Antibody |
| Immunogen |
CatNo: Eg0539 Product name: Recombinant Human AFP protein (His Tag) Source: mammalian cells-derived, pHZ-KIsec-C-6*HIS Tag: C-6*HIS Domain: 19-609 aa of BC027881 Sequence: RTLHRNEYGIASILDSYQCTAEISLADLATIFFAQFVQEATYKEVSKMVKDALTAIEKPTGDEQSSGCLENQLPAFLEELCHEKEILEKYGHSDCCSQSEEGRHNCFLAHKKPTPASIPLFQVPEPVTSCEAYEEDRETFMNKFIYEIARRHPFLYAPTILLWAARYDKIIPSCCKAENAVECFQTKAATVTKELRESSLLNQHACAVMKNFGTRTFQAITVTKLSQKFTKVNFTEIQKLVLDVAHVHEHCCRGDVLDCLQDGEKIMSYICSQQDTLSNKITECCKLTTLERGQCIIHAENDEKPEGLSPNLNRFLGDRDFNQFSSGEKNIFLASFVHEYSRRHPQLAVSVILRVAKGYQELLEKCFQTENPLECQDKGEEELQKYIQESQALAKRSCGLFQKLGEYYLQNAFLVAYTKKAPQLTSSELMAITRKMAATAATCCQLSEDKLLACGEGAADIIIGHLCIRHEMTPVNPGVGQCCTSSYANRRPCFSSLVVDETYVPPAFSDDKFIFHKDLCQAQGVALQTMKQEFLINLVKQKPQITEEQLEAVIADFSGLLEKCCQGQEQEVCFAEEGQKLISKTRAALGV Predict reactive species |
| Full Name | alpha-fetoprotein |
| Calculated Molecular Weight | 69 kDa |
| Observed Molecular Weight | 68 kDa |
| GenBank Accession Number | BC027881 |
| Gene Symbol | AFP |
| Gene ID (NCBI) | 174 |
| RRID | AB_3670732 |
| Conjugate | Unconjugated |
| Form | Liquid |
| Purification Method | Protein A purfication |
| UNIPROT ID | P02771 |
| Storage Buffer | PBS with 0.02% sodium azide and 50% glycerol, pH 7.3. |
| Storage Conditions | Store at -20°C. Stable for one year after shipment. Aliquoting is unnecessary for -20oC storage. 20ul sizes contain 0.1% BSA. |
Background Information
AFP (Alpha-fetoprotein) is a major plasma protein in the fetus and its concentration is very low in the adult (PMID:24120489). AFP can be detected at abnormally high concentrations in hepatocellular carcinomas as well as in the plasma and ascitic fluid of adults with hepatoma, indicating that AFP can serve as a tumor marker (PMID: 18669658). AFP is also a glycosylated protein and based on its binding capability to lectin Lens Culinaris Agglutinin (LCA), and total AFP can be separated into three different glycoforms, AFP-L1, AFP-L2, and AFP-L3. Core-fucosylated form of AFP (AFP-L3) is a more specific indicator than total AFP for HCC (PMID: 33128033, 35458505)
Protocols
| Product Specific Protocols | |
|---|---|
| IHC protocol for AFP antibody 82982-6-RR | Download protocol |
| WB protocol for AFP antibody 82982-6-RR | Download protocol |
| Standard Protocols | |
|---|---|
| Click here to view our Standard Protocols |